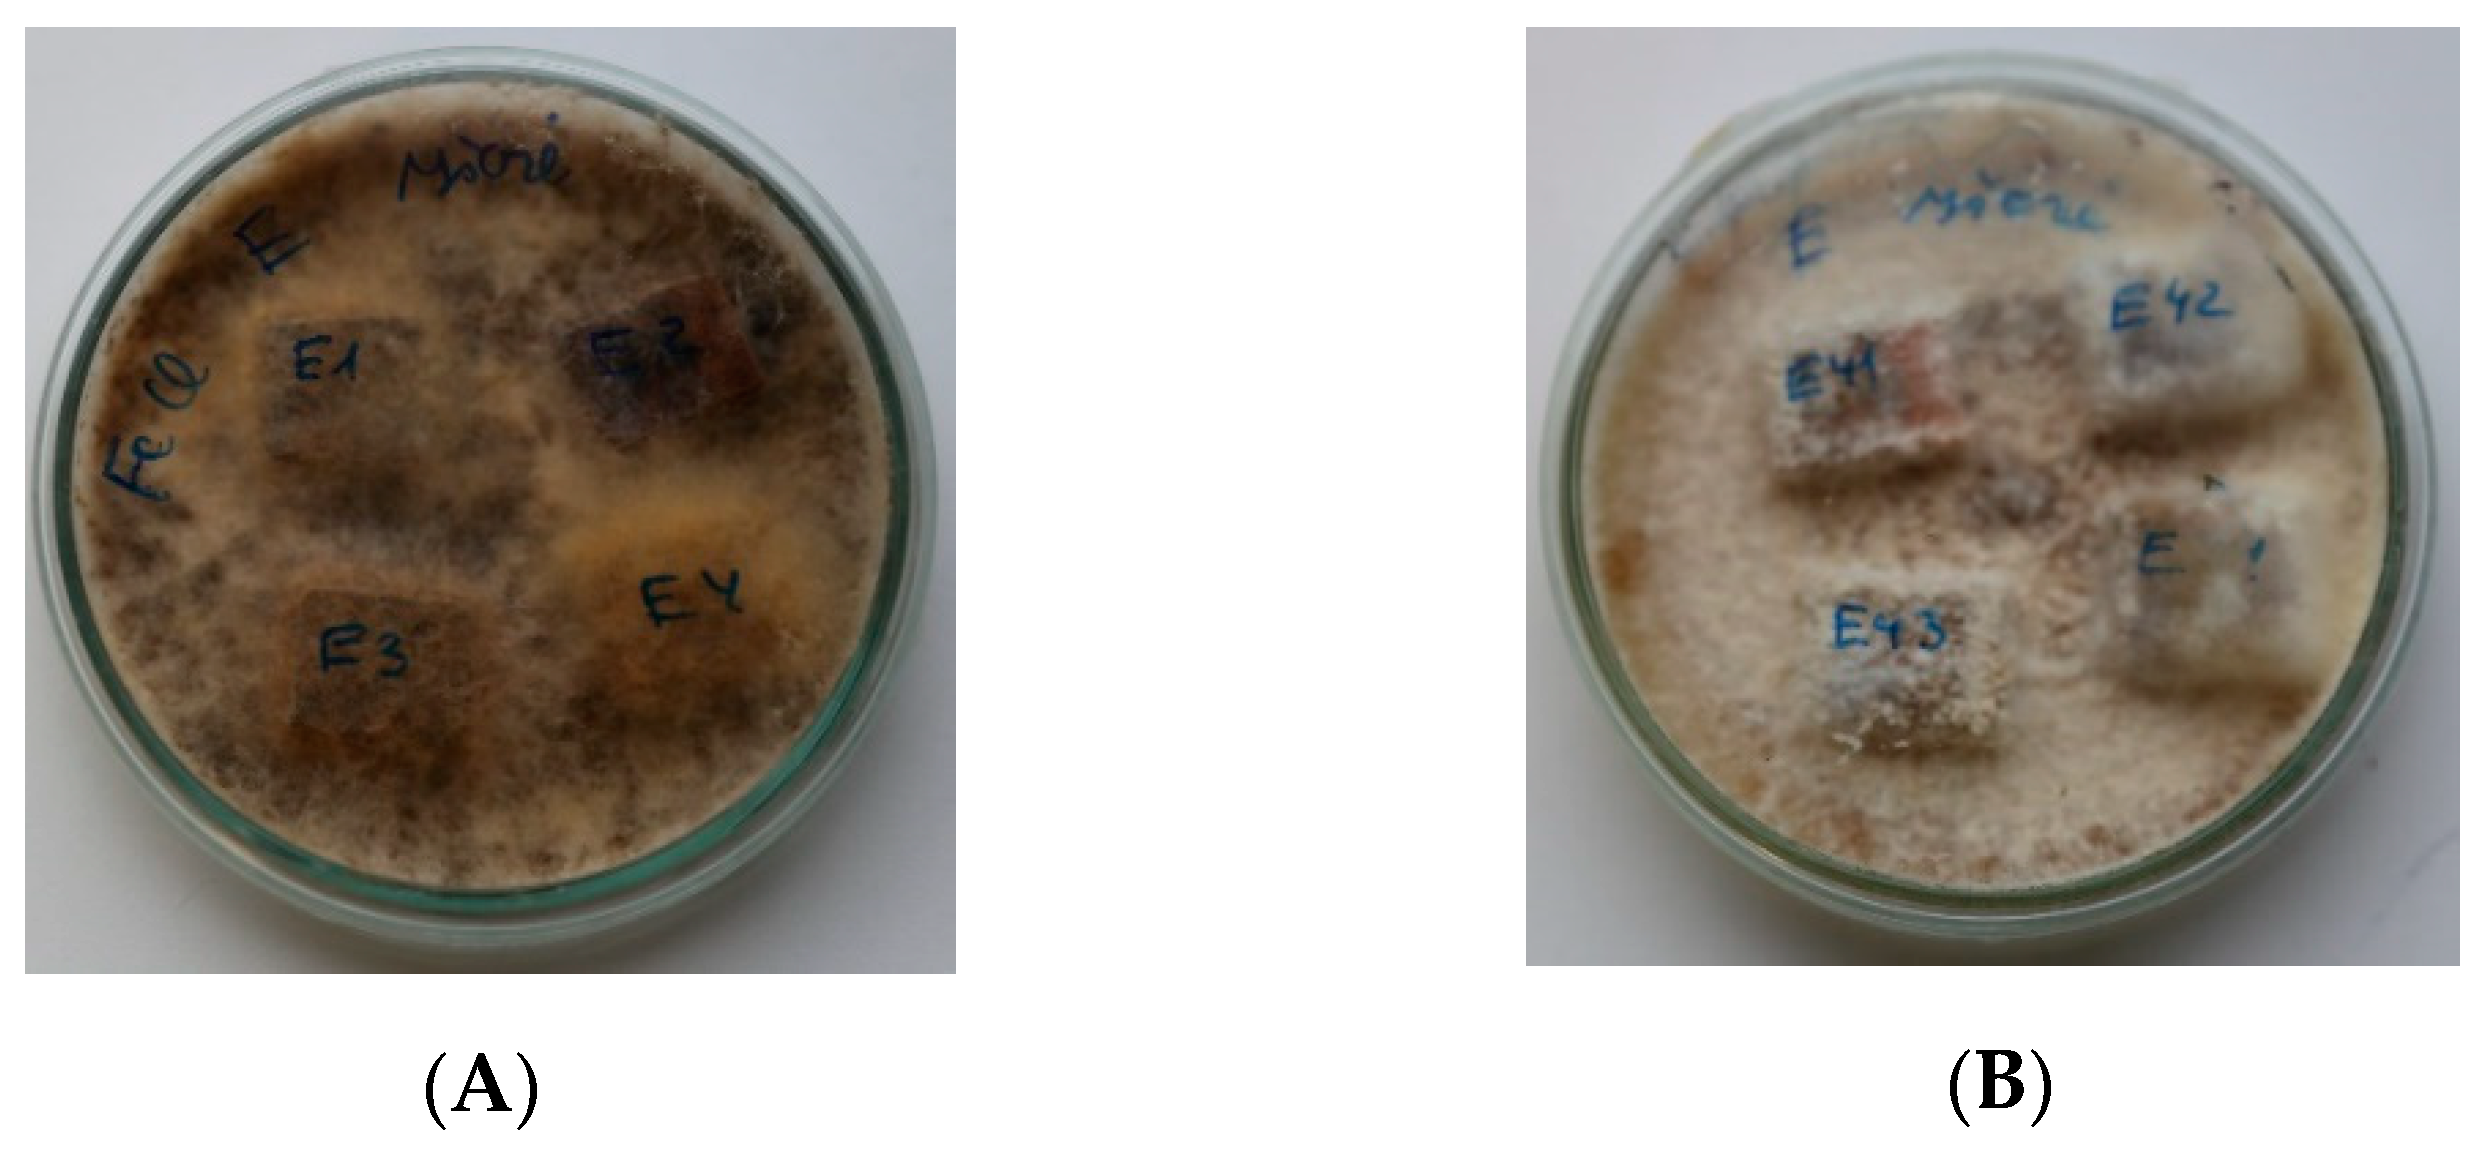
Forests 12 00645 g002 Forests 12 00645 g002
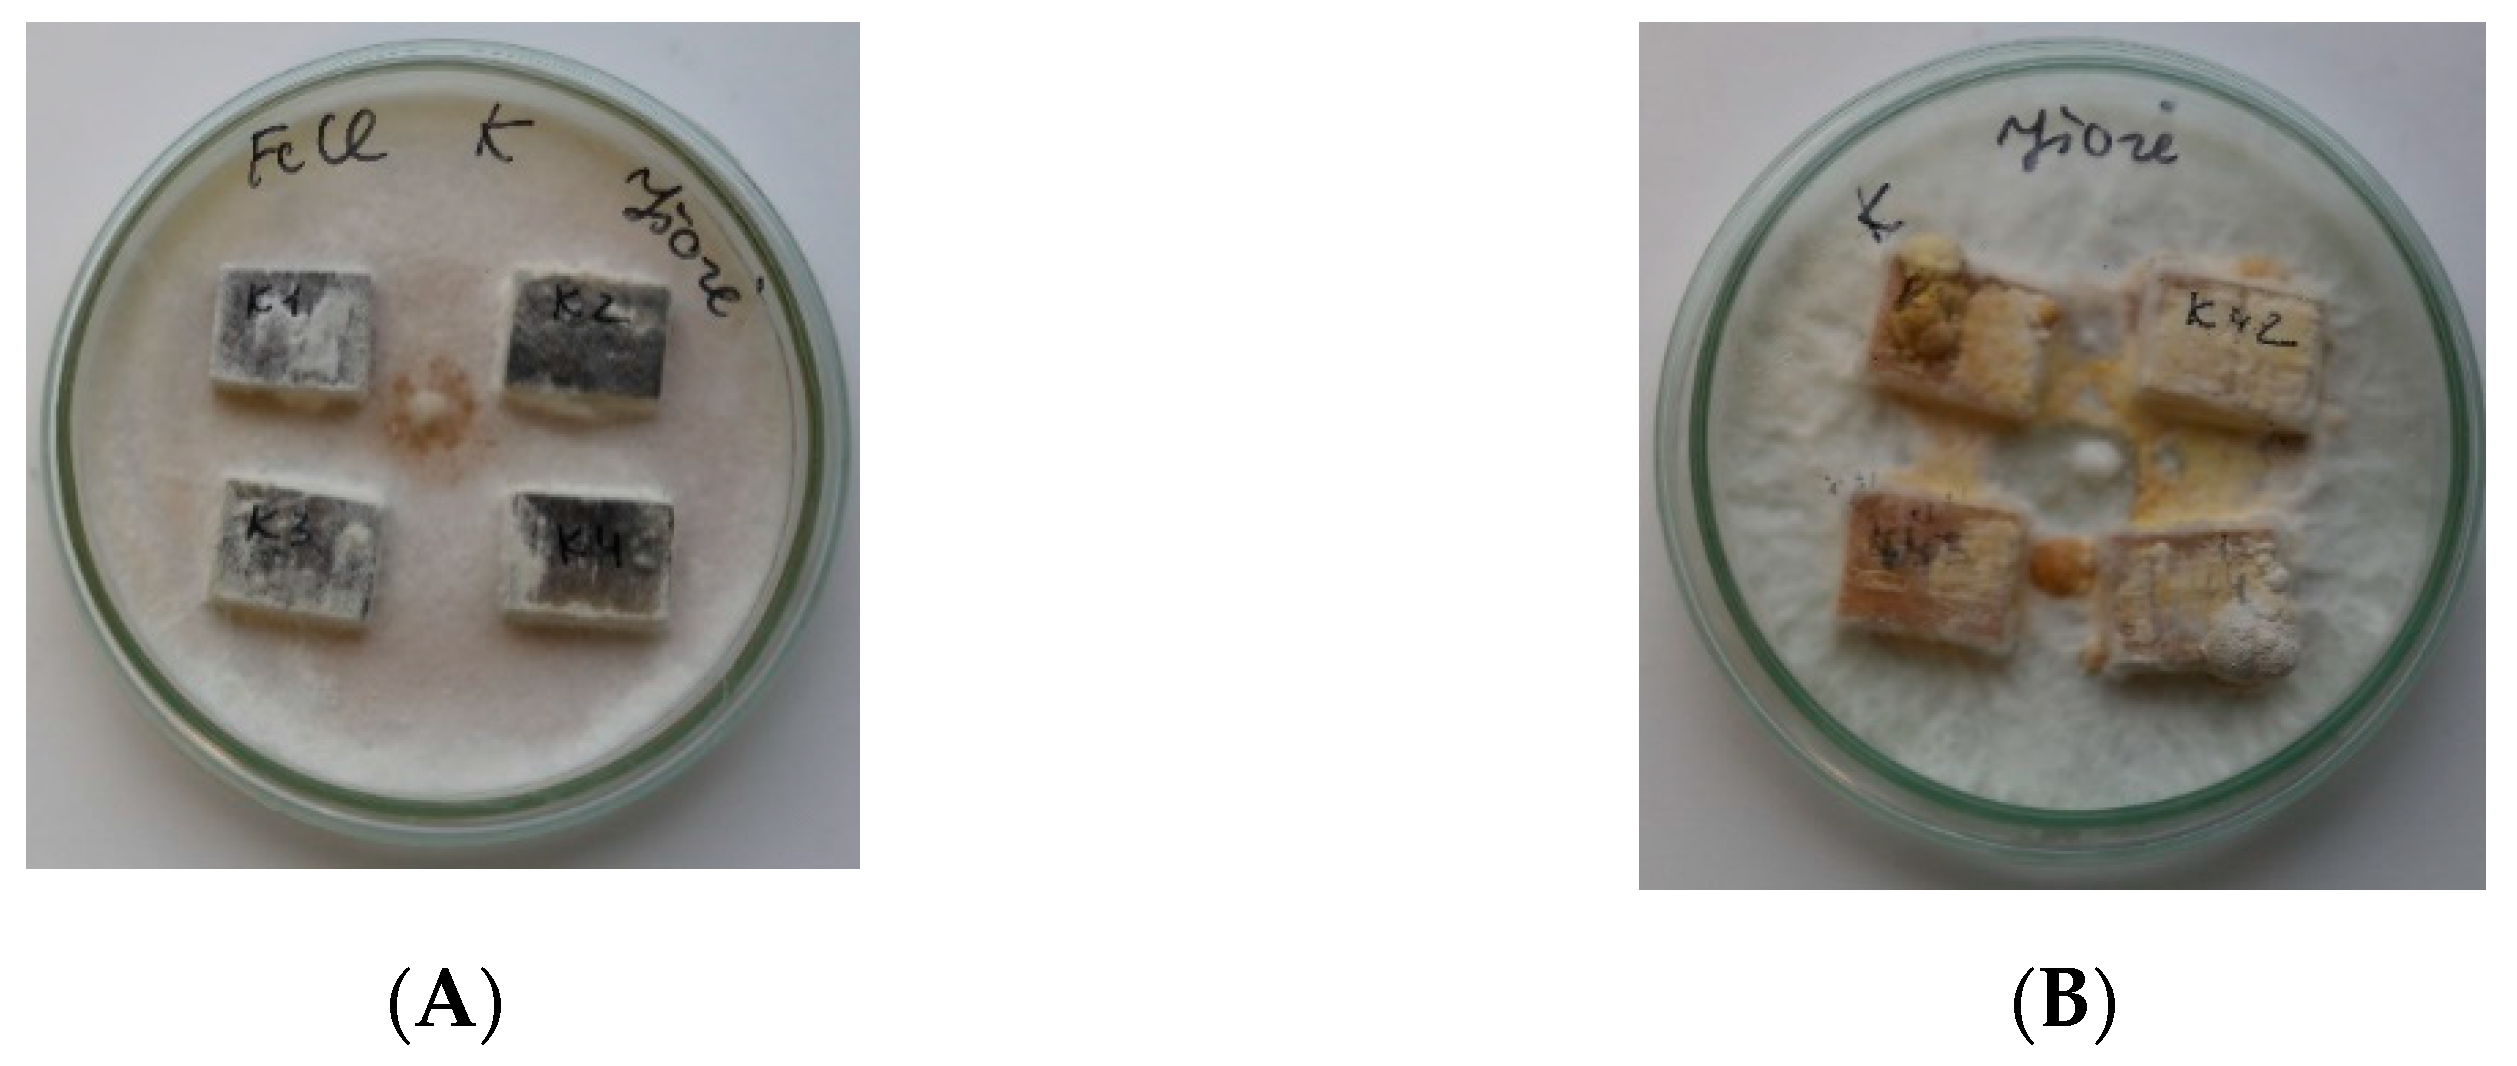
Forests 12 00645 g003 Forests 12 00645 g003

Resistance of Wood Treated with Iron Compounds against Wood-Destroying Decay and Mould Fungi
Abstract
1. Introduction
2. Materials and Methods
2.1. Wood Treatment
2.2. Fungal Decay Test
2.3. Mould Test
2.4. Statistical Analyses
3. Results
3.1. Weight Loss of Modified Wood Caused by White and Brown Rot Fungi
3.2. Wood Response to Mould Test
4. Discussion
5. Conclusions
Author Contributions
Funding
Acknowledgments
Conflicts of Interest
References
- Råberg, U.; Edlund, M.L.; Terziev, N.; Land, C.J. Testing and evaluation of natural durability of wood in above ground conditions in Europe—An overview. J. Wood Sci. 2005, 51, 429–440. [Google Scholar] [CrossRef]
- Heseltine, E.; Rosen, J. World Health Organisation Guidelines for Indoor Air Quality: Dampness and Moulds; WHO: Copenhagen, Denmark, 2009; pp. 31–61. [Google Scholar]
- Highley, T.L. Biodeterioration of wood. In Wood Handbook—Wood as an Engineering Material; General Technical Report FPLGTR-113; Department of Agriculture, Forest Service, Forest Products Laboratory: Madison, WI, USA, 1999; pp. 13-1–13-16. [Google Scholar]
- Reinprecht, L. Structural Protection of Wood. In Wood Deterioration, Protection and Maintenance; John Wiley & Sons, Ltd.: Chichester, UK, 2016; pp. 126–144. [Google Scholar] [CrossRef]
- Greaves, H. The bacterial factor in wood decay. Wood Sci. Technol. 1971, 5, 6–16. [Google Scholar] [CrossRef]
- Eaton, R.; Hale, M.D.C. Wood, Decay, Pests and Protection, 1st ed.; Chapman and Hall: London, UK, 1993; 546p. [Google Scholar]
- Hill, C.A.S. Wood Modification: Chemical, Thermal and Other Processes; John Wiley & Sons, Ltd.: Chichester, UK, 2006; pp. 19–44. [Google Scholar] [CrossRef]
- Goodell, B.; Qian, Y.; Jellison, J. Fungal decay of wood: Soft rot-brown rot-white rot. In Development of Commercial Wood Preservatives: Efficacy, Environmental, and Health Issues; Schultz, T.P., Militz, H., Freeman, M.H., Goodell, B., Nicholas, D.D., Eds.; American Chemical Society: Washington, DC, USA, 2008; pp. 9–31. [Google Scholar]
- Ghosh, S.C.; Militz, H.; Mai, C. Decay resistance of treated wood with functionalised commercial silicones. BioResources 2008, 3, 1303–1314. [Google Scholar]
- Curling, S.; Clausen, C.A.; Winandy, J.E. Relationships between mechanical properties, weight loss, and chemical composition of wood during brown rot decay. For. Prod. J. 2002, 52, 34–39. [Google Scholar]
- Schmidt, O. Holz- und Baumpilze: Biologie, Schaden, Schutz, Nutzen. [Wood and Tree Fungi: Biology, Decay, Protection, Use]; Springer: Berlin, Germany, 1994; pp. 77–84. [Google Scholar]
- Sutter, H.P. Holzschädlinge an Kulturgütern Erkennen und Bekämpfen. [Recognize and Combat Wood Pests on Cultural Goods]; Paul Haupt: Bern, Switzerland, 2002; 166p. [Google Scholar]
- Robbins, C.; Morrell, J. Mold, Housing and Wood; Western Wood Products Association: Portland, OR, USA, 2002; pp. 1–7. [Google Scholar]
- Salminen, K.; Peuhkuri, R.; Lähdesmäki, K.; Viitanen, H.; Vinha, J.; Paajanen, L.; Iitti, H.; Ojanen, T.; Strander, T. Mould growth in building materials in laboratory and field experiments. In Proceedings of the 9th Nordic Symposium on Building Physics NSB, Tampere, Finland, 29 May–2 June 2011; pp. 859–866. [Google Scholar]
- Karlsson, O.; Yang, Q.; Sehlstedt-Persson, M.; Moren, T. Heat treatments of high temperature dried Norway spruce boards: Saccharides and furfurals in sapwood surfaces. BioResources 2012, 7, 2284–2299. [Google Scholar] [CrossRef][Green Version]
- Vidholdova, Z.; Iždinsky, J.; Reinprecht, L.; Krokošova, J. Activity of bacteria and molds on surfaces of commercial wooden composites. Mater. Sci. Forum 2015, 818, 190–193. [Google Scholar] [CrossRef]
- Hens, H.L.S.C. Fungal defacement in buildings: A performance related approach. HVAC&R Res. 1999, 5, 256–280. [Google Scholar]
- Hukka, A.; Viitanen, H. A mathematical model of mould growth on wooden material. Wood Sci. Technol. 1999, 33, 475–485. [Google Scholar] [CrossRef]
- Viitanen, H.; Ritschkoff, A. Mould Growth in Pine and Spruce Sapwood in Relation to Air Humidity and Temperature; Report no 221; The Swedish University of Agricultural Sciences, Department of Forest Products: Uppsala, Sweden, 1991; 49p. [Google Scholar]
- Gorny, R.L. Filamentous microorganisms and their fragments in indoor air—A review. Ann. Agric. Environ. Med. 2004, 11, 185–197. [Google Scholar]
- Adan, O.C.G.; Huinink, H.P.; Bekker, M. Water relations of indoor fungi. In Fundamentals of Mold Growth in Indoor Environments and Strategies for Healthy Living; Adan, O.C.G., Samson, R.A., Eds.; Wageningen Academic Publishers: Wageningen, The Netherlands, 2011; pp. 41–65. [Google Scholar]
- Baughman, A.V.; Arens, E.A. Indoor humidity and human health-part I: Literature review of health effects of humidity-influences indoor pollutants. ASHRAE Trans. 1996, 102, 193–211. [Google Scholar]
- Viitanen, H.; Bjurman, J. Mould growth on wood under fluctuating humidity conditions. Mater. Org. 1995, 29, 27–46. [Google Scholar]
- Reinprecht, L.; Panek, M.; Dankova, J.; Murinova, T.; Mec, P.; Plevova, L. Performance of methyl-tripotassium silanol treated wood against swelling in water, decay fungi and moulds. Wood Res. 2013, 58, 511–520. [Google Scholar]
- Vidholdova, Z.; Reinprecht, L.; Igaz, R. The impact of laser surface modification of beech wood on its color and occurence of molds. BioResources 2017, 12, 4177–4186. [Google Scholar] [CrossRef]
- Myronycheva, O.; Sehlstedt-Persson, M.; Karlsson, O.; Sandberg, D. Growth of Mold and Rot Fungi on Copper-impregnated Scots Pine Sapwood: Influence of Planing Depth and Inoculation Pattern. BioResources 2018, 13, 8787–8801. [Google Scholar] [CrossRef]
- Schultz, T.P.; Nicholas, D.D. Development of environmentally-benign wood preservatives based on the combination of organic biocides with antioxidants and metal chelators. Phytochemistry 2002, 61, 555–560. [Google Scholar] [CrossRef]
- Kartal, S.N.; Munir, E.; Kakitani, T.; Imamura, Y. Bioremediation of CCA-treated wood by brown-rot fungi Fomitopsis palustris, Coniophora puteana and Laetiporus sulphureus. J. Wood Sci. 2004, 50, 182–188. [Google Scholar] [CrossRef]
- Cao, Y.; Lu, J.; Huang, R.; Zhao, Y.; Wu, Y. Evaluation of decay resistance for steam-heat-treated wood. Bioresources 2011, 6, 4696–4704. [Google Scholar]
- Myronycheva, O.; Poohphajai, F.; Sehlstedt-Persson, M.; Vikberg, T.; Karlsson, O.; Junge, H.; Sandberg, D. Application of GRAS Compuonds for the Control of Mould Growth on Scots Pine Sapwood Surfaces: Multivariate Modelling of Mould Grade. Forests 2019, 10, 714. [Google Scholar] [CrossRef]
- Kartal, S.N.; Hwang, W.; Imamura, Y.; Sekine, Y. Effect of essential oil compounds and plant extracts on decay and termite resistance of wood. Holz. Roh. Werkst. 2006, 64, 455–461. [Google Scholar] [CrossRef]
- Maoz, M.; Weitz, I.; Blumenfeil, M.; Freitag, C.; Morrell, J.J. Antifungal Activity of Plant Derived Extracts against G. trabeum; No. IRG/WP 07-30433; International Research Group on Wood Protection: Stockholm, Sweden, 2007. [Google Scholar]
- Viitanen, H.; Jämsä, S.; Paajanen, L.; Nurmi, A.; Viitaniemi, P. The Effect of Heat Treatment on the Properties of Spruce; No. IRG/ WP 94-40032; International Research Group on Wood Preservation: Stockholm, Sweden, 1994. [Google Scholar]
- Kamdem, D.P.; Pizzi, A.; Guyonnet, R.; Jermannand, A. Durability of Heat—Treated Wood. Holz als Roh- und Werkstoff 1999, 60. [Google Scholar] [CrossRef]
- Tjeerdsma, B.; Stevens, M.; Militz, H. Durability Aspects of Hydrothermal Treated Wood; No. IRG/WP 00-40160; Section 4-Processes; International Research Group Wood Preservation: Stockholm, Sweden, 2000. [Google Scholar]
- Welzbacher, C.; Rapp, O. Comparison of Thermally Modified Wood Originating from Four Industrial Scale Processes-Durability; No. IRG/WP 02-40229; Section 4-Processes; International Research Group Wood Preservation: Stockholm, Sweden, 2002. [Google Scholar]
- Esteves, B.; Pereira, H. Wood modification by heat treatment: Review. Bioresources 2009, 4, 370–404. [Google Scholar] [CrossRef]
- Homan, W.; Tjeerdsma, B.; Beckers, E.; Jorissen, A. Structural and other properties of modified wood. In Proceedings of the World Conference on Timber Engineering, Whistler Resort, BC, Canada, 31 July–3 August 2000; p. 8. [Google Scholar]
- Lekounougou, S.; Petrissans, M.; Jacquot, J.P.; Gelhaye, E.; Gerardin, P. Effect of heat treatment on extracellular enzymatic activities involved in beech wood degradation by Trametes versicolor. Wood Sci. Technol. 2009, 43, 331–341. [Google Scholar] [CrossRef]
- European Standard EN 113. Wood Preservatives—Method of Test for Determining the Protective Effectiveness against Wood Destroying Basidiomycetes—Determination of the Toxic Values; European Committee for Standardization: Brussels, Belgium, 1996. [Google Scholar]
- Crisostomo, M.C.; Del Menezzi, C.H.S. Evaluation of the Effect of Thermo-mechanical Treatment on the Resistance of Commercial OSB to Decay Fungi. Mater. Sci. 2019, 25, 190–194. [Google Scholar] [CrossRef]
- European Standard EN 15457 (2007): Paints and Varnishes—Laboratory Method for Testing the Efficacy of Film Preservatives in a Coating Against Fungi; European Committee for Standardization: Brussels, Belgium, 2007.
- El Abed, S.; Hamadi, F.; Latrache, H.; Iraqui, H.M.; Ibnsouda, K.S. Adhesion of Aspergillus niger and Penicillium expansumspores on Fez cedar wood substrata. Ann. Microbiol. 2010, 60, 377–382. [Google Scholar] [CrossRef]
- Sandberg, D.; Kutnar, A.; Mantanis, G. Wood modification technologies—A review. iForest 2017, 10, 895–908. [Google Scholar] [CrossRef]
- Tiralova, Z.; Reinprecht, L. Fungal decay of acrylate treated wood. In Proceedings of the Conference: 35th Annual Meeting IRG/WP 04-30357 The international research group on wood preservation, Section 3 Wood Protecting Chemicals, Ljubljana, Slovenia, 6–10 June 2004. [Google Scholar] [CrossRef]
- Xiao, Z.; Xie, Y.; Mai, C. The fungal resistance of wood modified with glutaraldehyde. Holzforschung 2012, 66, 237–243. [Google Scholar] [CrossRef]
- Boonstra, M.J.; Van Acker, J.; Tjeerdsma, B.F.; Kegel, E.V. Strength properties of thermally modified softwoods and its relation to polymeric structural wood constituents. Ann. For. Sci. 2007, 64, 679–690. [Google Scholar] [CrossRef]
- Sivrikaya, H.; Can, A.; De Troya, T.; Conde, M. Comparative biological resistance of differently thermal modified wood species against decay fungi, Reticulitermes grassei and Hylotrupes bajulus. Maderas Cienc. Tecnol. 2015, 17, 559–570. [Google Scholar] [CrossRef]
- Leithoff, H.; Peek, R.D. Heat treatment of Bamboo. In Proceedings of the International Research Group on Wood Preservation. Section 4. Paper prepared for the 32nd Annual Meeting, Nara, Japan, 20–25 May 2001. IRG/WP 10-40216. [Google Scholar]
- Ayata, U.; Akcay, C.; Esteves, B. Determination of decay resistance against Pleurotus ostreatus and Coniophora puteana fungus of heat-treated scotch pine, oak and beech wood species. Maderas Cienc. Tecnol. 2017, 19, 309–316. [Google Scholar] [CrossRef]
- Yalcin, M.; Sahin, H.I. Changes in the chemical structure and decay resistance of heat-treated narrow-leaved ash wood. Maderas Cienc. Tecnol. 2015, 17, 435–446. [Google Scholar] [CrossRef]
- Goodell, B.; Winandy, J.E.; Morrell, J.J. Fungal Degradation of Wood: Emerging Data, New Insights and Changing Perceptions. Coatings 2020, 10, 1210. [Google Scholar] [CrossRef]
- Curling, S.; Winandy, J.E.; Clausen, C.A. An experimental method to simulate incipient decay of wood basidiomycete fungi. In Proceedings of the International Research Group on Wood Preservation. Section 2, Test Methodology and Assessment (IRG/WP 00-20200), 31st Annual Meeting, Kona, HI, USA, 14–19 May 2000; pp. 1–12. [Google Scholar]
- Ohno, K.M.; Clausen, C.A.; Green, F.; Diehl, S.V. Insights into the mechanism of copper-tolerance in Fibroporia radiculosa: The biosynthesis of oxalate. Int. Biodeterior. Biodegrad. 2015, 105, 90–96. [Google Scholar] [CrossRef]
- Gadd, G.M. The geomycology of elemental cycling and transformations in the environment. In The Fungal Kingdom; ASM Press: Washington, DC, USA, 2017; pp. 371–386. [Google Scholar] [CrossRef]
- Philp, R.W.; Bruce, A.; Munro, A.G. The effect of water soluble Scots pine (Pinus sylvestris L.) and Sitka spruce (Picea sitchensis (Bong.) Carr.) heartwood and sapwood extracts on the growth of selected Trichoderma species. Int. Biodeterior. Biodegrad. 1995, 35, 355–367. [Google Scholar] [CrossRef]
- Xu, K.M.; Feng, J.; Zhong, T.H.; Zheng, Z.F.; Chen, T.A. Effects of volatile chemical components of wood species on mould growth susceptibility and termite attack resistance of wood plastic composites. Int. Biodeterior. Biodegrad. 2015, 100, 106–115. [Google Scholar] [CrossRef]
- Schmidt, O.; Magel, E.; Fruhwald, A.; Glukhykh, L.; Erdt, K.; Kaschuro, S. Influence of sugar and starch content of palm wood on fungal development and prevention of fungal colonization by acid treatment. Holzforschung 2016, 70, 783–791. [Google Scholar] [CrossRef]
- Johansson, P.; Mjornell, K.; Arfvidsson, J. Examples of characteristics of wood that affect mould growth: A meta-analysis. Eur. J. Wood Prod. 2017, 75, 603–613. [Google Scholar] [CrossRef]
- Feng, J.; Li, C.; Chen, J.; Chen, M.; Shu, X.; Shi, Q. Evaluation of the association between natural mold resistance and chemical components of nine wood species. Bioresources 2018, 13, 6524–6541. [Google Scholar] [CrossRef]
- Reinprecht, L.; Vidholdova, Z.; Izdinsky, J. Bacterial and mold resistance of selected tropical wood species. Bioresources 2020, 15, 5198–5209. [Google Scholar]
- Taylor, A.M.; Gartner, B.L.; Morrell, J.J. Heartwood formation and natural durability: A review. Wood Fiber Sci. 2002, 34, 587–611. [Google Scholar]
- Gobakken, L.R.; Westin, M. Surface mould growth on five modified wood substrates coated with three different coating systems when exposed outdoors. Int. Biodeterior. Biodegrad. 2008, 62, 397–402. [Google Scholar] [CrossRef]
- Anouhe, J.B.S.; Niamke, F.B.; Faustin, M.; Virieux, D.; Pirat, J.L.; Adima, A.A.; Kati-Coulibaly, S.; Amusant, N. The role of extractives in the natural durability of the heartwood of Dicorynia guianensis Amsh: New insights in antioxydant and antifungal properties. Ann. For. Sci. 2018, 75, 15. [Google Scholar] [CrossRef]

| Rating Level | Percentage Area of Disfigurements |
|---|---|
| 0 | No growth on the surface of the sample |
| 1 | Up to 10% growth on the surface of the sample |
| 2 | More than 10% up to 30% growth on the surface of the sample |
| 3 | More than 30% up to 50% growth on the surface of the sample |
| 4 | More than 50% up to 100% growth on the surface of the sample |
| Tree Species | Treatment | Weight Loss Due to Fungi Effect (%) | |||
|---|---|---|---|---|---|
| Trametes versicolor | Coniophora puteana | ||||
| Pine | FeCl3 | 4.37 (0.47) | b | 14.75 (2.76) | d |
| FeCl3 + tannins | 3.95 (0.47) | b | 25.43 (2.05) | c | |
| Fe2O3 | 3.58 (0.66) | b | 42.29 (1.15) | ab | |
| Fe2O3 + tannins | 11.84 (0.63) | a | 35.94 (1.70) | b | |
| Control 1 * | 16.39 (2.11) | a | 39.41 (0.87) | ab | |
| Control 2 * | 5.70 (1.57) | b | 44.68 (2.40) | a | |
| Spruce | FeCl3 | 3.17 (0.52) | cd | 15.35 (2.11) | d |
| FeCl3 + tannins | 4.17 (0.24) | bc | 16.61 (1.74) | cd | |
| Fe2O3 | 3.94 (0.95) | cd | 31.29 (2.78) | b | |
| Fe2O3 + tannins | 11.32 (0.77) | a | 35.55 (3.94) | b | |
| Control 1 | 7.60 (1.55) | b | 29.56 (4.43) | bc | |
| Control 2 | 0.45 (0.14) | d | 57.02 (3.22) | a | |
| Fir | FeCl3 | 3.59 (0.37) | ab | 19.44 (2.93) | bc |
| FeCl3 + tannins | 1.46 (0.19) | c | 14.68 (0.71) | c | |
| Fe2O3 | 2.75 (0.53) | bc | 32.54 (3.91) | ab | |
| Fe2O3 + tannins | 1.21 (0.31) | c | 21.37 (2.34) | bc | |
| Control 1 | 4.02 (0.48) | ab | 31.74 (1.30) | ab | |
| Control 2 | 4.78 (0.55) | a | 38.70 (5.52) | a | |
| Maple | FeCl3 | 17.36 (1.74) | cd | 15.94 (1.48) | b |
| FeCl3 + tannins | 15.49 (0.59) | d | 18.64 (1.56) | ab | |
| Fe2O3 | 35.13 (5.89) | ab | 29.69 (3.34) | a | |
| Fe2O3 + tannins | 31.04 (2.74) | bc | 21.70 (1.82) | ab | |
| Control 1 | 48.10 (4.94) | a | 26.28 (3.21) | ab | |
| Control 2 | 43.49 (3.20) | ab | 26.70 (5.35) | ab | |
| Walnut | FeCl3 | 15.07 (0.54) | cd | 18.22 (1.68) | b |
| FeCl3 + tannins | 11.61 (0.83) | d | 19.19 (1.56) | b | |
| Fe2O3 | 25.05 (2.00) | a | 30.76 (0.96) | a | |
| Fe2O3 + tannins | 17.80 (2.16) | bc | 23.97 (4.75) | ab | |
| Control 1 | 24.14 (0.90) | a | 27.77 (2.28) | ab | |
| Control 2 | 22.16 (0.31) | ab | 20.69 (3.11) | ab | |
| Tree Species | Treatment | Aspergillus niger | Penicillium sp. | Mean Mould Rating *** | ||
|---|---|---|---|---|---|---|
| Mean | Range (SE) ** | Mean | Range (SE) | |||
| Pine | FeCl3 | 10.6 | 0–30(4.1) | 33.8 | 0–80(11.0) | 2.5 |
| FeCl3 + tannins | 38.1 | 5–90(11.7) | 16.8 | 3–50(5.8) | 2.9 | |
| Fe2O3 | 86.3 | 40–100(7.3) | 4.5 | 0–20(2.3) | 3.9 | |
| Fe2O3 + tannins | 63.1 | 40–95(7.9) | 8.8 | 0–20(2.3) | 4.0 | |
| Control 1 * | 93.8 | 85–100(2.1) | 16.3 | 5–30(3.2) | 4.0 | |
| Control 2 * | 58.8 | 40–70(3.5) | 46.3 | 10–70(6.8) | 4.0 | |
| Spruce | FeCl3 | 0.0 | 0 | 0.0 | 0 | 0.0 |
| FeCl3 + tannins | 6.3 | 0–15(1.8) | 4.6 | 0–10(1.3) | 1.5 | |
| Fe2O3 | 75.0 | 20–100(8.7) | 11.9 | 0–20(2.8) | 3.8 | |
| Fe2O3 + tannins | 60.6 | 30–100(9.3) | 10.8 | 1–20(2.3) | 3.5 | |
| Control 1 | 91.9 | 80–100(2.5) | 22.5 | 5–40(4.4) | 4.0 | |
| Control 2 | 75.0 | 50–90(5.4) | 31.3 | 10–60(5.8) | 4.0 | |
| Fir | FeCl3 | 2.9 | 0–5(0.9) | 0.0 | 0.00 | 0.6 |
| FeCl3 + tannins | 5.9 | 1–15(1.6) | 0.4 | 0–3(0.4) | 1.1 | |
| Fe2O3 | 34.0 | 15–70(7.2) | 3.6 | 0–10(1.5) | 2.9 | |
| Fe2O3 + tannins | 47.5 | 20–80(8.4) | 8.1 | 5–10(0.9) | 3.3 | |
| Control 1 | 88.8 | 60–100(4.7) | 6.9 | 0–20(2.8) | 4.0 | |
| Control 2 | 71.3 | 30–90(7.4) | 9.8 | 3–20(2.2) | 3.9 | |
| Maple | FeCl3 | 40.6 | 5–70(8.9) | 21.3 | 0–80(9.0) | 3.1 |
| FeCl3 + tannins | 36.9 | 5–90(11.5) | 7.5 | 0–25(3.5) | 2.6 | |
| Fe2O3 | 96.3 | 80–100(2.6) | 13.1 | 5–30(3.8) | 4.0 | |
| Fe2O3 + tannins | 58.8 | 30–90(7.2) | 0.0 | 0.00 | 3.4 | |
| Control 1 | 91.9 | 80–100(3.3) | 21.9 | 5–50(5.0) | 4.0 | |
| Control 2 | 90.6 | 80–100(2.0) | 27.5 | 5–50(5.2) | 4.0 | |
| Walnut | FeCl3 | 5.9 | 0–20(2.5) | 11.3 | 0–20(2.8) | 1.6 |
| FeCl3 + tannins | 26.9 | 5–100(10.9) | 6.9 | 0–20(3.0) | 2.4 | |
| Fe2O3 | 72.5 | 60–90(4.5) | 18.8 | 0–50(6.6) | 4.0 | |
| Fe2O3 + tannins | 43.8 | 5–100(12.3) | 2.3 | 0–10(1.3) | 2.6 | |
| Control 1 | 86.9 | 70–100(3.3) | 10.0 | 0–25(2.8) | 4.0 | |
| Control 2 | 98.1 | 90–100(1.3) | 3.9 | 0–10(1.1) | 4.0 | |
Publisher’s Note: MDPI stays neutral with regard to jurisdictional claims in published maps and institutional affiliations. |
© 2021 by the authors. Licensee MDPI, Basel, Switzerland. This article is an open access article distributed under the terms and conditions of the Creative Commons Attribution (CC BY) license (https://creativecommons.org/licenses/by/4.0/).
Share and Cite
Aleinikovas, M.; Varnagirytė-Kabašinskienė, I.; Povilaitienė, A.; Šilinskas, B.; Škėma, M.; Beniušienė, L. Resistance of Wood Treated with Iron Compounds against Wood-Destroying Decay and Mould Fungi. Forests 2021, 12, 645. https://doi.org/10.3390/f12050645
Aleinikovas M, Varnagirytė-Kabašinskienė I, Povilaitienė A, Šilinskas B, Škėma M, Beniušienė L. Resistance of Wood Treated with Iron Compounds against Wood-Destroying Decay and Mould Fungi. Forests. 2021; 12(5):645. https://doi.org/10.3390/f12050645
Chicago/Turabian StyleAleinikovas, Marius, Iveta Varnagirytė-Kabašinskienė, Aistė Povilaitienė, Benas Šilinskas, Mindaugas Škėma, and Lina Beniušienė. 2021. "Resistance of Wood Treated with Iron Compounds against Wood-Destroying Decay and Mould Fungi" Forests 12, no. 5: 645. https://doi.org/10.3390/f12050645
APA StyleAleinikovas, M., Varnagirytė-Kabašinskienė, I., Povilaitienė, A., Šilinskas, B., Škėma, M., & Beniušienė, L. (2021). Resistance of Wood Treated with Iron Compounds against Wood-Destroying Decay and Mould Fungi. Forests, 12(5), 645. https://doi.org/10.3390/f12050645

